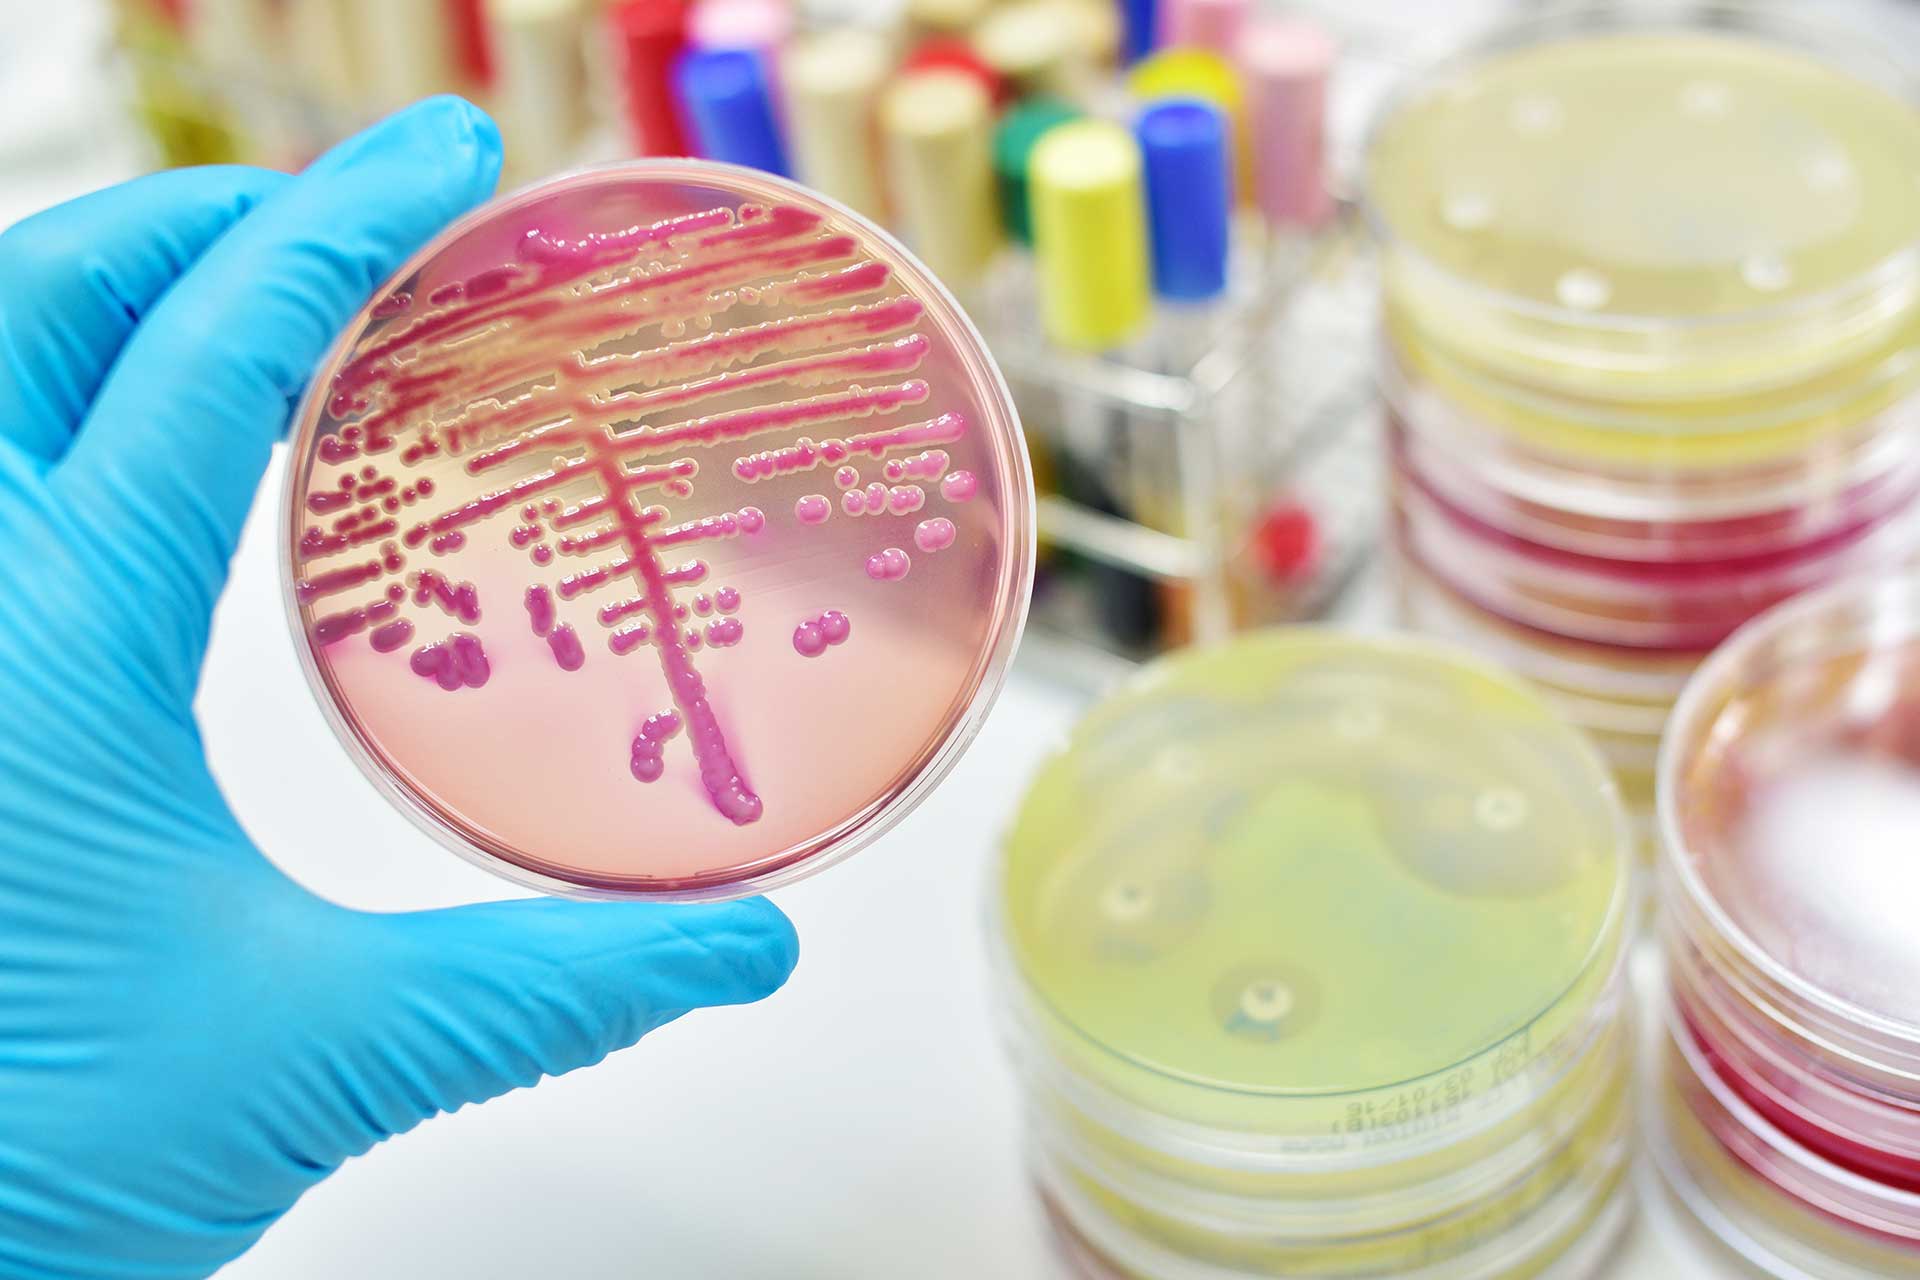
urologicum duisburg diagnostic-mikrobiologie

Das Urologicum Duisburg bietet aus reinem Selbstverständnis seinen Patienten das bestmögliche Spektrum urologischer Diagnostik unter strenger Einhaltung geltender Qualitätsstandards.
Urinlabor: Untersuchung mittels Urinstreifentest und mikroskopische Analyse des Urinsedimentes
Die Urinuntersuchung stellt ein grundlegendes diagnostisches Hilfsmittel in der Medizin dar. Dabei wird die die Zusammensetzung und Beschaffenheit des Urins untersucht, um so Erkrankungen der Harnwege oder auch andere innere Erkrankungen zu diagnostizieren bzw. auszuschließen.
Mikrobiologie (Untersuchung auf Krankheitserreger im Urin)
Bei Nachweis einer Harnwegsinfektion im Urin wird automatisch eine sog. Urinkultur angelegt. Nach Bebrütung des Urins werden die Bakterienkulturen mittels Analyzer identifiziert und ein sog. Antibiogramm angefertigt, welches dem Behandler die entscheidende Information in der Antibiotikawahl einer Harnwegsinfektion liefert. Nur durch diese gezielte Therapie kann eine unnötige Antibiotikagabe verhindert werden, die sonst zu Resistenzen führen kann.
Durch eine vollständige Bearbeitung der Proben im eigenen Labor mittels eines Analyzers stehen die Ergebnisse nach 24-48 Stunden bereits zur Verfügung.
Urinzytologie zur Früherkennung und Nachsorge des Harnblasenkrebses
NMP22-Test zur Früherkennung von Harnblasenkrebs
Blutlabor
- Allgemeine Laborparameter
- Quantitative Bestimmung von Tumormarkern für Prostata-, Darm- und Hodenkrebs (gesamt PSA, freies PSA, CEA, CA19-9, AFP, ß-HCG/HCG)
- Hormonlabor (Testosteron, SHBG, freier Androgen Index, LH, FSH, DHEA, Östradiol, Prolaktin) zur Hormonstatusprüfung
Immunologischer Stuhltest
Diagnostik sexuell übertragbarer Infektionen (STD) durch spezielle Erreger (Mykoplasmen/Ureaplasmen, Chlamydien, Gonorrhoe, Trichomonaden) im Urin, Abstrichen und Ejakulat.
Spermiogramm
Standarisierte Ejakulatanalyse nach den Richtlinien der WHO zur Beurteilung der Zeugungsfähigkeit des Mannes bei unerfülltem Kinderwunsch.
Die Ultraschalldiagnostik (Sonographie) ist das bildgebende Verfahren der ersten Wahl in der Urologie und bildet die Basis in der Diagnostik urologischer Erkrankungen. Die Sonographie ist nicht invasiv und schmerzlos. Für den erfahrenen Urologen lassen sich die urologischen Organe einfach und zuverlässig untersuchen.
Mit Ultraschallgeräten der neuesten Generation bieten wir folgendes Untersuchungssprektrum an:
- Ultraschalluntersuchung des Bauchraumes (Nieren, Blase, Bauchaortenscreening zum Aneurysmaausschluss)
- Männliche Genitalien (Hoden, Nebenhoden, Penis, Prostata)
- TRUS (Ultraschall der Prostata vom Enddarm aus) mit gezielter Gewebeentnahme
- Farbdoppler-Ultraschall der Gefäße von Penis und Hoden zur Überprüfung der Durchblutung
Im Rahmen der Blasenspiegelung (Zystoskopie) wird ein optisches Untersuchungsinstrument (starres oder flexibles Instrument) über die Harnröhre bis in die Blase geführt. Somit kann der Urologe Veränderungen der Blase und der Harnröhre diagnostizieren. Die Untersuchung wird in Lokalanästhesie durchgeführt.
Es gibt verschiedene Indikationen für eine Blasenspiegelung:
- Wiederkehrende Entzündungen der Harnblase oder der Harnröhre
- Blut im Urin
- Blasenentleerungsstörungen
- Verdacht auf einen Blasentumor/ Nachsorge nach Harnblasenkarzinom
- Steinleiden
- Entfernung von operativ eingesetzten Harnleiterschienen
In besonderen Situationen können wir die Zystoskopie auch in Narkose anbieten.
Durch Röntgenuntersuchungen in der Urologie kann entweder das gesamte ableitende Harnsystem oder ein spezieller Bereich untersucht werden. Die meisten urologischen Röntgenuntersuchungen werden mit Kontrastmittel durchgeführt.
- Infusionsurogramm
Diese Röntgenuntersuchung der Nieren, der Harnleiter und der Blase ermöglicht die Diagnostik von Tumoren des ableitenden Harnsystems, exakte Lokalisation und Darstellung von Steinen und Harnabflusstörungen. - Urethrogramm
Durch Einbringen eines Kontrastmittels in die Harnröhre wird diese auf mögliche Engstellen untersucht. - Miktions-Cysto-Urogramm (MCU)
Beim sog. MCU wird eine Röntgenuntersuchung der Harnblase beim Wasserlassen durchgeführt. Dies lässt einen Rückschluss darauf zu, ob ein Rückfluss des Urines in die Harnleiter oder sogar die Nieren besteht. Ein solcher Reflux kann zu wiederkehrenden Harnwegsinfekten und zu fieberhaftem Nierenbeckenentzündungen führen.
Unter einer urdynamischen Untersuchung versteht man eine mitunter therapieentscheidende Funktionsuntersuchung der ableitenden Harnwege zur Abklärung einer Harninkontinenz, überaktiven Blase und Blasenentleerungsstörung.
Die urodynamischen Untersuchungen umfassen die Uroflowmetrie (Harnstrahlmessung), die Blasendruckmessung mittels eines dünnen Harnkatheters, das Harnröhrendruckprofil zur Messung der Schließmuskelstärke und die Elektromyographie zur Aufzeichnung der Beckenbodenaktivität.
Blasenfunktionsstörungen können folgende Ursachen haben:
- Gutartige Prostatavergrößerung mit einer Blasenentleerungsstörung
- Altersbedingte Störungen des Blasenmuskels und der Nervenversorgung der Blase
- Neurologische Erkrankungen wie z.B die multiple Sklerose oder der M. Parkinson
- Senkungen der Gebärmutter oder Blase
- Stoffwechselstörungen wie z.B. der Diabetes mellitus, der zu eine Nervenstörung der Harnblase führen kann
- Operationen im Becken ebenfalls mit Folge einer Nervenstörung
Mit Hilfe der urodynamischen Untersuchungen können diese Ursachen differenziert werden. Sie werden in unserer Praxis ambulant angeboten.